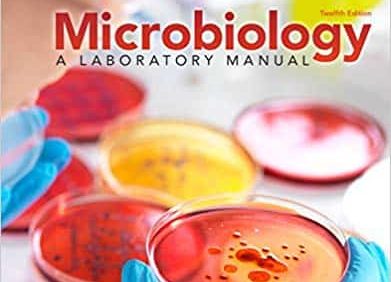
Microbiology: A Laboratory Manual (12th Edition) – PDF

Engineering Dynamics 2.0: Fundamentals and Numerical Solutions – eBook PDF Engineering Dynamics 2.0 (PDF) offers a new approach to learning the dynamics of particles and rigid bodies at an intermediate to advanced level. There are three prominent features of this approach. First, the primary focus is to obtain the equations of motion of dynamical systems and to solve them numerically. As a result, most of the analytical exercises and homework found in traditional dynamics textbooks written at this level are substituted by MATLAB®-based simulations. Second, broad use is made of matrices. Matrices are vital to defining the important role that...
Engineering Dynamics 2.0: Fundamentals and Numerical Solutions – PDF